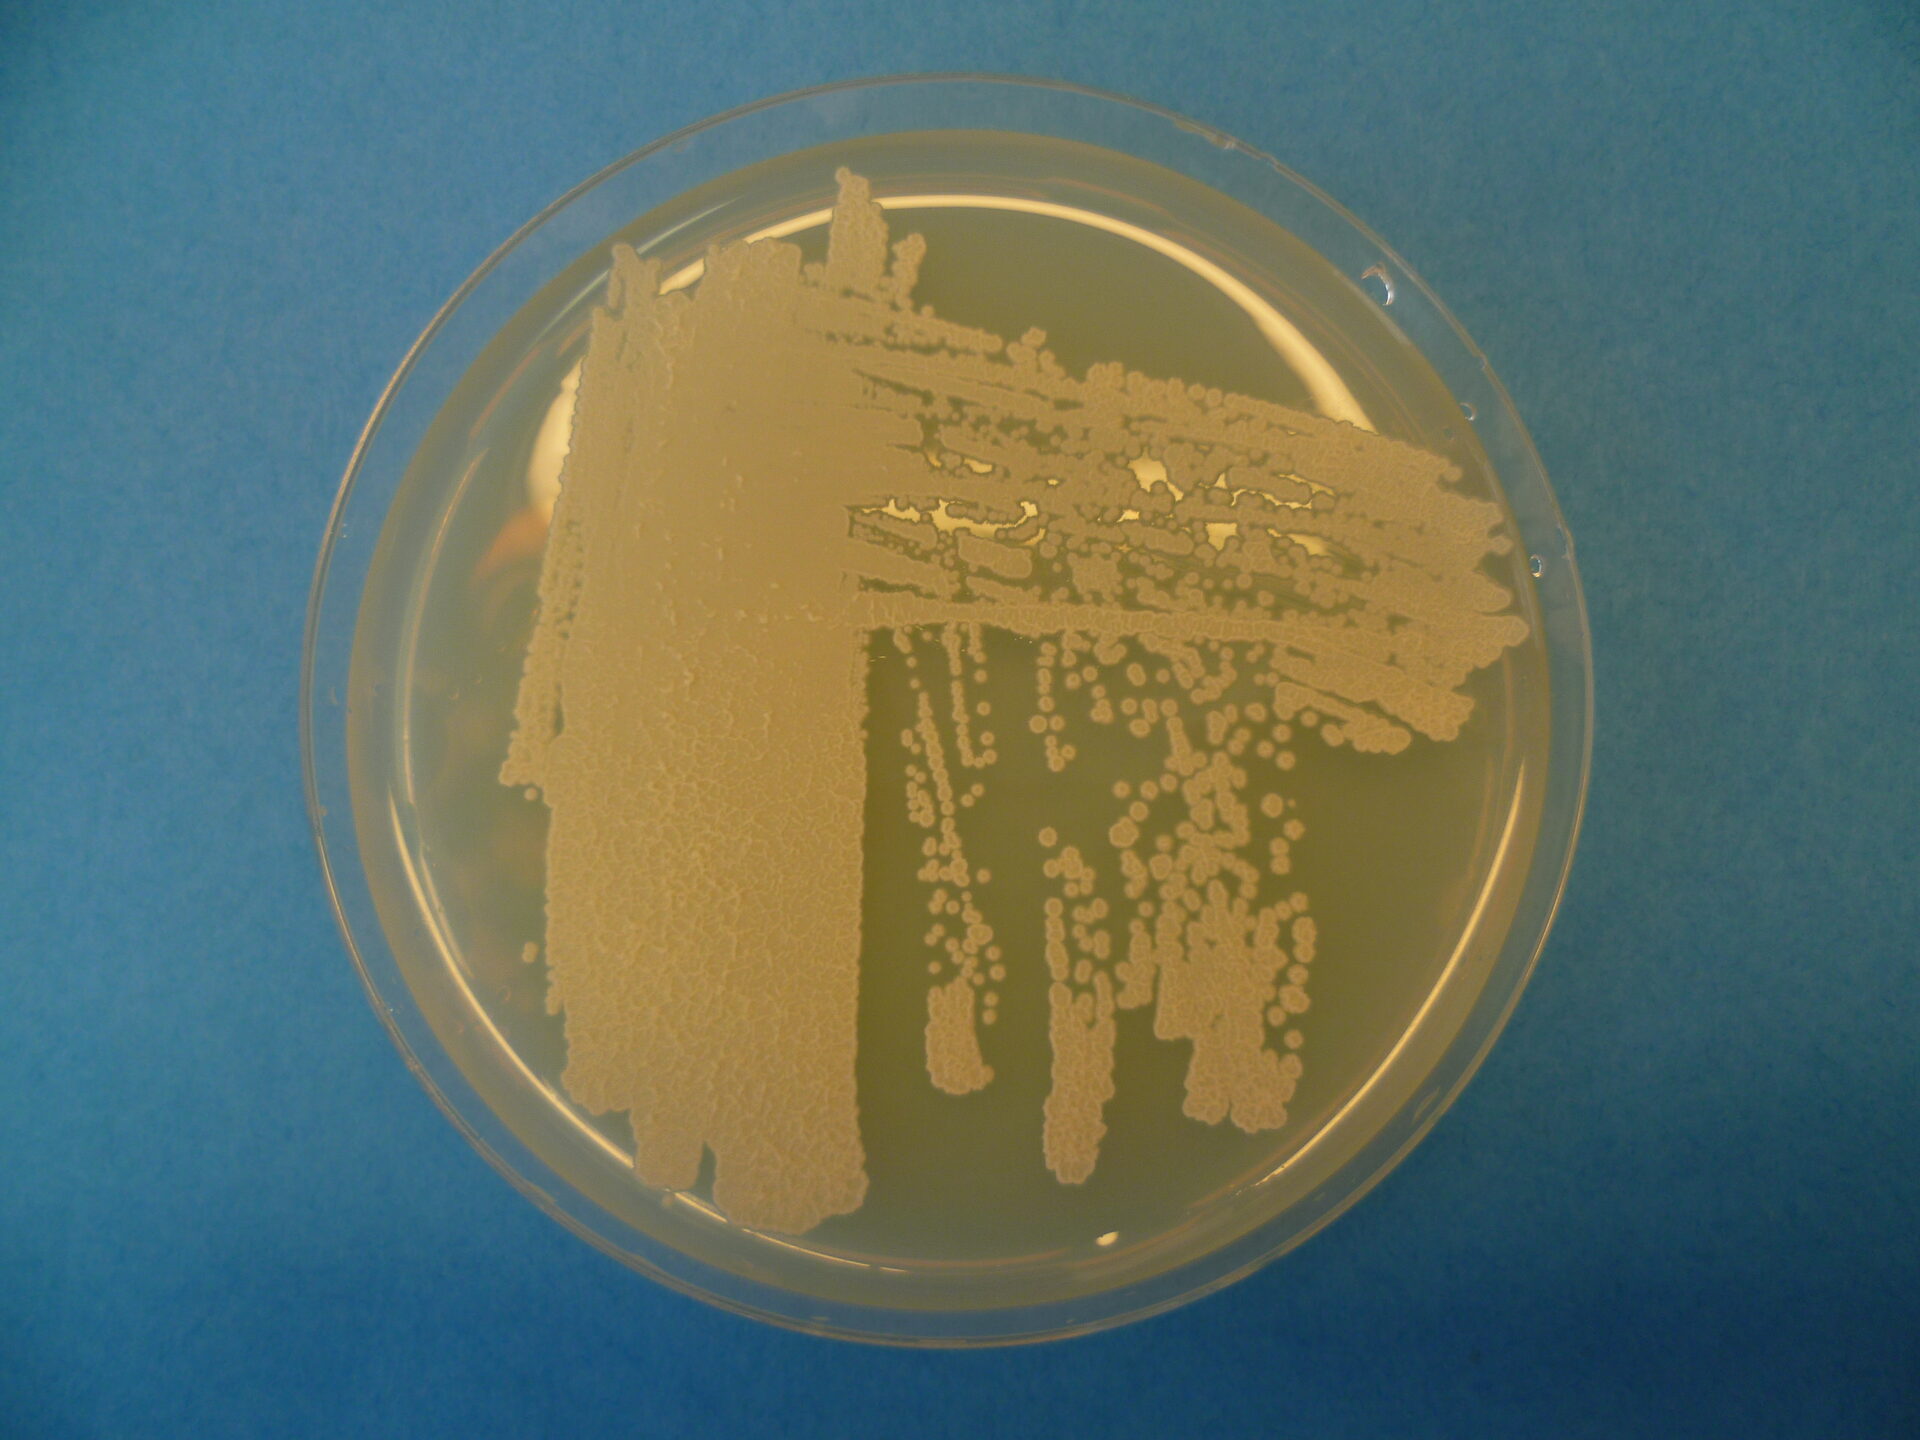

Vom Produktionsrest zum Rohstoff: Kreislaufwirtschaft in der Lebensmittelindustrie
Vom Produktionsrest zum Rohstoff: Kreislaufwirtschaft in der Lebensmittelindustrie
Der Aufbau einer funktionierenden Kreislaufwirtschaft ist eine der großen Herausforderungen moderner Industrien. Die Lebensmittelindustrie steht dabei besonders im Fokus, da ihre Rohstoffe größtenteils von begrenzt verfügbaren landwirtschaftlichen Nutzflächen stammen und mit erheblichem Ressourcenverbrauch erzeugt werden. Ein von der DBU gefördertes Verbundprojekt zeigt am Beispiel der Riegelherstellung, wie praktikable Lösungen in der Praxis aussehen können. Dabei werden Nebenströme und Reststoffe genutzt, die in vielen Produktionsprozessen anfallen, bislang jedoch kaum genutzt werden. Insbesondere bei der Herstellung von Protein-, Energie- und Schokoriegeln fallen kontinuierlich erhebliche Mengen an Produktionsresten an. Dabei handelt es sich hauptsächlich um überschüssige Teigabschnitte sowie über- oder untergewichtige Produkte. Aufgrund ihrer Beschaffenheit können sie nicht unmittelbar in den Herstellungsprozess zurückgeführt werden. Aktuell werden diese Reststoffe überwiegend entsorgt oder einer thermischen Verwertung zugeführt, obwohl sie noch wertvolle Inhaltsstoffe für eine weitere Verwendung enthalten.
Projektidee mit Hefe im Fokus
An dieser Stelle setzt das gemeinsame Projekt der anona GmbH, des Helmholtz-Zentrums für Umweltforschung GmbH – UFZ und des Instituts für Nichtklassische Chemie e. V. (INC) an. Ziel des Vorhabens ist es, einen praktikablen und nachhaltigen Lösungsansatz zu entwickeln, mit dem biogene Reststoffe aus der Riegelherstellung und anderen Produktionslinien wertschöpfend genutzt und wieder als Rohstoffe in die betriebliche Produktion zurückgeführt werden können.
Ausgangspunkt ist dabei der Einsatz der Hefeart Yarrowia lipolytica, mit deren Hilfe Riegelteigreste und weitere geeignete Nebenströme in Citronensäure und proteinhaltige Biomasse umgewandelt werden können – und damit in wertvolle biobasierte Produkte.
Die Lebensmittelbranche soll diese Stoffe perspektivisch erneut als Roh- bzw. Ausgangsstoffe in ihren Produktionsprozessen verwenden können. Deshalb entwickelt das Projektteam parallel an effizienten Verfahren zur Aufarbeitung der Citronensäure und bewertet die neu gewonnenen Ausgangsstoffe sowohl aus ökologischer als auch aus ökonomischer Sicht. Das Projekt zeigt modellhaft, wie industrielle Produktionsprozesse und biotechnologische Innovation miteinander verknüpft werden können, um eine Grundlage für eine ressourcenschonende und zukunftsfähige Lebensmittelproduktion zu schaffen.
Riegelteig ressourcenoptimiert herstellen
Bereits in der Vergangenheit hat die anona GmbH im Rahmen eines DBU-Projektes (DBU-AZ: 37926) neue Impulse für die Riegelteigverarbeitung gesetzt. In der Branche fehlten lange Zeit klare Regeln dafür, wie Knetprozesse, beispielsweise bei Rezepturänderungen, zuverlässig vom Labormaßstab in den industriellen Prozess übertragen werden können. Stattdessen basierten die Einstellungen auf Erfahrungswerten und Schätzungen. Das kann neben instabilen technischen Abläufen zu nicht verwertbaren Fehlproduktionen und damit zu erheblichen Verlusten von Ressourcen wie Lebensmittelrohstoffen, Energie, Wasser, Personal und Zeit führen. Durch verlässliche Kennzahlen können Knetprozesse optimiert, der Ressourcenaufwand verringert und der gesamte Produktionsprozess nachhaltiger gestaltet werden.
Vor diesem Hintergrund entwickelte das Projektteam kennzahlenbasierte Maßstabsübertragungsregeln, die unmittelbar in die Produktionsabläufe unter Praxisbedingungen übernommen werden konnten. Auch die Bewertung hinsichtlich der Wirtschaftlichkeit und der Umweltauswirkungen fiel positiv aus.
Projektdurchführung
Helmholtz-Zentrum für Umweltforschung GmbH – UFZ
Dept. Systemische Umweltbiotechnologie (SUBT)
Permoserstr. 15
04315 Leipzig
DBU-AZ: 38407/01
Förderzeitraum: 01.01.2024 – 30.09.2025